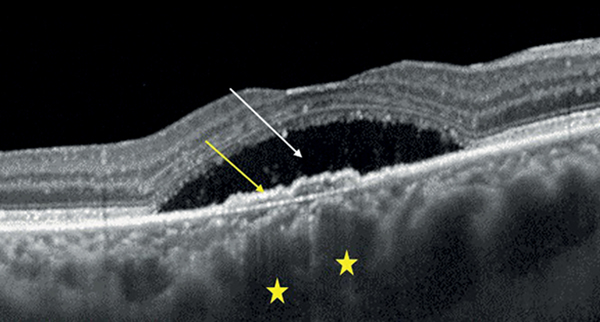

The morphological characterisation of wet age-related macular degeneration subtypes and pachychoroid neovasculopathy
doi: 10.55342/szemhungarica.2025.162.3.102
Review
Summary
Distinguishing the subtypes of wet age-related macular degeneration (AMD) is of paramount importance, as the course of the disease and the response to therapy among the subtypes may differ. With the development of certain imaging procedures and the possibility of multimodal imaging, the differentiation of wet AMD subtypes and the identification of pachychoroid neovasculopathy (PNV) have become easier. The aim of this article is to describe the subtypes of wet AMD and pachychoroid neovasculopathy using multimodal imaging, with special emphasis on OCT-based diagnostics as a tool with high diagnostic precision that is now more readily available in our country.
Összefoglaló
A nedves típusú időskori makuladegeneráció (nAMD) altípusainak differenciálása kiemelt jelentőségű, hiszen az altípusok betegség lefolyása, valamint a terápiára adott válasza eltérhet. Az egyes képalkotó eljárások fejlődésével és a multimodális képalkotás lehetőségével a különböző nedves AMD altípusok elkülönítése és a pachychorioidealis neovasculopathia (PNV) azonosítása könnyebbé vált. Jelen cikk célja a nedves AMD altípusainak, valamint a pachychorioidealis neovasculopathiának ismertetése és differenciálása multimodális képalkotás segítségével, különös hangsúlyt fektetve az OCT-alapú diagnosztikára, mint egy ma már hazánkban is könnyebben hozzáférhető magas diagnosztikus precizitással bíró diagnosztikus eszközre.Keywords
wet age-related macular degeneration, pachychoroid neovasculopathy, retinal angiomatous proliferation, polypoidal choroidal vasculopathy
Kulcsszavak
nedves típusú időskori makuladegeneráció, pachychoioidealis neovasculopathia, retinalis angiomatosus proliferáció, polypoid chorioidealis vasculopathia
<a href=” “> </a>
Bevezetés
Az időskori makuladegeneráció (AMD) a súlyos látásromlás kialakulásának egyik vezető oka, amely az 50 év feletti lakosságot érintheti. Nedves AMD esetén a neovaszkularizáció, míg geografikus atrófia esetén az atrofizálódás okoz látásromlást (25).
A nedves AMD patofiziológiai jellegzetességeit elsőként Gass írta le 1967-ben, amelyhez akkor még csupán színes fundusfotók és fluoreszcein-angiográfia (FLAG) szolgált alapul (14).
Azóta viszont az indocianin-zöld angiográfia (ICGA), optikai koherencia tomográfia (OCT), valamint az optikai koherencia tomográfia angiográfia (OCTA), mint innovatív diagnosztikus technikák megjelenésével elérhetővé vált a multimodális képalkotás, amelynek segítségével a neovaszkularizáció morfológiai jellegzetességei és pontos helye precízen meghatározható lett (43).
Míg korábban chorioidealis neovaszkularizációról (CNV) beszéltünk nedves AMD kapcsán, a multimodális képalkotásnak köszönhetően ma már a makuláris neovaszkularizáció (MNV) a helyes terminológia ezzel is hangsúlyozva azt, hogy a neovaszkularizáció nemcsak a chorioideából, hanem a retina ereiből is származhat nedves AMD-ben (44).
Csak maga az OCT-képalkotás olyan fejlődésen esett át az 1991-es fejlesztése óta (18), hogy az utóbbi években sorra jelennek meg a magas szenzitivitású és specificitású OCT diagnosztikai kritériumokat tartalmazó tanulmányok, amelyek segítségével a legtöbb esetben a még nem kezelt nedves AMD-típusok jól differenciálhatók egymástól (5, 8, 22, 37).
A nedves AMD altípusainak pontos meghatározása azért is nagy jelentőségű, mivel azok terápiára adott válasza anatómiai és funkcionális szempontból különböző. Fontos azonban azt is megjegyezni, hogy az időben történő differenciálás segítséget nyújthat a személyre szabott kezelés megtervezésében, és hozzájárulhat a pontosabb prognózis felállításához (20, 29).
A pachychorioidealis neovasculopathia (PNV) makuláris neovaszkularizációval járó kórkép, amely a pachychorioidealis spektrumbetegségek közé sorolandó. 2015-ben Pang és Freund írták le először önálló entitásként (36).
Besorolásának jelentőségét az adja, hogy önálló betegségként való leírása előtt, de még azóta is az életkori átfedés miatt gyakran kerül nedves AMD-ként diagnosztizálásra. A nedves AMD-től való elkülönítésére azért van szükség, mert mindkét kórfolyamatnak más az etiológiája, más a terápiára adott válasza és funkcionális kimenetele (15, 26).
Az egyes nedves AMD altípusok, valamint a PNV differenciálása
2020-ban a CONAN (Consensus on Neovascular AMD Nomenclature) nemzetközi szakértői munkacsoport a nedves AMD korszerű nevezéktanát dolgozta ki. Retinaspecialisták, képalkotó szakértők és patológusok egységesítették a nedves AMD különböző altípusainak meghatározását.
Míg korábban a nedves AMD talajú CNV-t típusos/klasszikus nedves AMD (nAMD), polypoid chorioidealis vasculopathia (PCV) és retinalis angiomatosus proliferáció (RAP) osztályokba sorolták, a CONAN javaslata alapján az új terminológia a makuláris neovaszkularizáció, amely magába foglalja az intraretinalis, subretinalis és sub-pigmentepithelialis (sub-RPE) érújdonképződést.
Tehát a CONAN kutatócsoport OCT- és OCTA-alapú új MNV anatómiai klasszifikációja a következő:
- 1-es típusú MNV: amely esetében az érújdonképződés a choriokapillárisokból származik és a retinalis pigmentepithelium (RPE) alá nő be és ott terjed. A PCV az 1-es típusú MNV alvariánsa, aneurizmás típusú 1-es MNV.
- 2-es típusú MNV: az érújdonképződés szintén a chorioideából származik, de az már áttöri az RPE szintjét és a subretinalis térben nő és terjed.
- 3-as típusú MNV: a neovaszkularizáció a retina saját érhálózatából indul, általában a mély kapilláris plexus erekből és a külső retina és chorioidea irányába terjed potenciálisan retino-chorioidealis anasztomózisok létrehozásával. Ezért esetében a chorioidealis neovaszkularizáció megnevezés tehát helytelen (1. ábra) (44).

Az 1-es típusú MNV szemfenéki képe nem típusos, mivel az ereződés az RPE rétege alatt helyezkedik el, nehezítve ezzel annak megítélését, de az összes MNV kísérőtüneteként potenciálisan megjelenő intra/subretinalis megvastagodás, vérzés, kemény exsudatio, illetve különböző pigmentepithel-leválások (PED) felhívhatják rá a figyelmet. OCT-felvételen az 1-es típusú MNV fibrovaszkuláris/vaszkularizált PED-ként ábrázolódik, az RPE-réteg megszakadásának hiányával. FLAG-képeken nem éles határú, késői, térben is fokozódó hiperfluoreszcenciát (leakage) mutat, gyakran többszörös pontszerű vagy foltos hiperfluoreszcenciával, amelyet okkult membránnak nevezünk. ICGA sem tudja igazán az ereket jól kirajzolni, inkább csak a neovaszkuláris hálózat egy késői festődését (staining) mutatja, amelyet plakként definiálunk. OCTA rendszerint szépen kirajzolja a sub-RPE-térben elhelyezkedő neovaszkuláris léziót. Az OCTA annyira meggyőző, hogy számos tanulmány ennek a vizsgálati módnak a szuperioritását mutatja 1-es típusú MNV detektálásában ICGA-val szemben (2. ábra) (12, 13, 19, 47).

2-es típusú MNV esetén az érújdonképződés a sub-RPE téren is áthalad, de elhelyezkedése a subretinalis térben dominál. A szemfenéki képen szemben az 1-es típussal szürkés-zöldes elváltozás látható a mély retinában, mivel a subretinalis térben elhelyezkedő léziót már nem fedi el a pigmentepithel. OCT-felvételen RPE-Bruch-membrán komplex megszakadása látható, valamint subretinalis hiperreflektivitás, amely korai stádiumban laza szerkezetű, de előrehaladott stádiumban, azaz fokozódó fibrosis során egészen reflektív és kompakt. Ezt nevezzük subretinalis hiperreflektív material-nak (SHRM), amely egy OCT biomarker. Az OCT-n látható SHRM tehát jelentheti magát a subretinalis térben elhelyezkedő neovaszkularizációt (kompaktabb megjelenés), vagy a bármilyen típusú MNV-ből származó vért, illetve fibrinnel kevert szérumot (lazább szerkezetű SHRM) a subretinalis térben. Jelenléte azonban leggyakrabban 2-es típusú MNV-re utal (42). A FLAG már korai hiperfluoreszcenciaként jól ábrázolja a neovaszkularizációt, amely időben és térben fokozódó hiperfluoreszcenciát fog mutatni (leakage), amelyet klasszikus membránként írhatunk le. OCTA jól mutatja az érújdonképződést az RPE szintje felett. 2-es típusú MNV esetén az ICGA kisebb diagnosztikus jelentőségű, viszont megmutathatja az MNV sub-RPE alatti részét is, amennyiben az jelentősebb mértékű, ezáltal mégis hozzájárulhat OCTA mellett a mix 1-es és 2-es típusú MNV leírásához (3. ábra) (29, 43, 44).

3-as típusú MNV jelenlétére jellegzetesek a szemfenéki képen megjelenő kis intraretinalis vérzések, amelyek mindig avaszkuláris zónán kívül, azaz extrafovealisan alakulnak ki. A vérzések mellett cisztoid űrök is jelen lehetnek, amelyek a vérzésekkel együtt akár már a neovaszkularizáció előtt létrejöhetnek. OCT-n cisztoid ödéma, illetve intraretinalis hiperreflektív massza/lézió jelenléte látható (I. stádium), amely subretinalisan (II. stádium) is terjedhet serosus PED kialakulását is előidézve, majd az RPE-t áttörve (törés látható az RPE szintjében) akár sub-RPE is növekedhet retino-chorioidealis anasztomózis létrehozásának lehetőségével, vaszkularizált PED kialakulásával (III. stádium). Az ereződés növekedésének irányát figyelembe véve tehát a 3-as típusú MNV 2-es, majd 1-es típusú MNV-t is létrehozhat, de minden esetben a retina ereiből kell, kiinduljon. FLAG korai intraretinalis fokális eresztést mutat, esetleges kapcsolódó cisztoid ödémával, illetve retino-retinalis vagy retino-chorioidealis anasztomózissal. Az ICGA apró késői hiperfluoreszcens hot spot-ként ábrázolja a 3-as típusú MNV-t. Az OCTA szépen kirajzolja az áramlás jelét az intraretinalis hiperreflektív massza területében (29, 43, 44, 51).
A 3-as típusú MNV nem más, mint a retinalis angiomatosus proliferáció. Ismerhetjük még retinalis vaszkuláris rendellenes komplexumként (retinal vascular anomalous complex) vagy okkult retino-chorioidealis anasztomózisként is, amelyhez gyakran szemfenéki képen reticularis pseudodrusenek társulnak (4. ábra) (2). 2001-ben elsőként Yanuzzi írta le, mint a nedves AMD egy különálló formáját (51). Kaukázusi populációban nedves AMD-n belüli prevalenciája 13%-15%, női predominanciával, és gyakrabban kétoldali megjelenéssel (11, 45).
A polypoid chorioidealis vasculopathia tulajdonképpen az 1-es típusú MNV egy variánsa. Yanuzzi és munkatársai írták le elsőként 1990-ben, akkor még a chorioidea vaszkuláris betegségének tulajdonítva azt (52). A típusos nedves AMD-vel összevetve PCV fiatalabb betegeket érint, és gyakrabban jelentkezik férfiaknál. Prevalenciája nedves AMD esetein belül ázsiai populációban 22%-62%, míg kaukázusiakban 10%-20% (6, 9). PCV esetén fokális vagy diffúz chorioidea-megvastagodás, azon belül is a mély chorioidea-réteg, a nagyereket tartalmazó Haller-réteg megvastagodása (pachyerek) és a felette lévő Sattler- és choriokapilláris rétegek komprimálása látható. Kialakulásában így szerepet játszhat a lokális hypoxia. PCV-re jellemző az elágazó érhálózat (branching neovascular network – BNN), valamint maguk a polypoid léziók, amelyek aneurizmaszerű vaszkuláris kitüremkedések (8). Mind a BNN, mind a polypoid léziók alatt találjuk a chorioidea fokális megvastagodásait. Ezen chorioidea megvastagodások jól megjeleníthetők és mérhetők non invazív módon EDI-OCT (enhanced depth imaging OCT), vagy en face OCT-technikával (5. ábra). A BNN a sub-RPE-térben helyezkedik el, míg a polypoid léziók ritkán akár az RPE-t is áttörhetik, de többnyire alatta találhatók (34). Szemfenéki képen a polypoid léziók narancsvörös nodulusokként jelenhetnek meg a makulában, illetve gyakran a peripapilláris régióban. A BNN erei legtöbbször nem válnak láthatóvá a felettük lévő RPE miatt, időnként azonban a retina ereinek kaliberével vetekedhetnek, mivel sokáig észrevétlenül tünetmentesen növekednek.

A polypoid léziók kialakulását serosanguinosus leválások kísérhetik, mivel azok vérzésre hajlamosak. Gyakran láthatunk nagyobb kiterjedésű subretinalis vérzéseket, vérzéses PED-eket, de a serosus PED-ek megjelenése sem ritka. OCT-felvételeken a PCV BNN része lapos, irreguláris vaszkularizált PED-ként jelenik meg, amelyet kettősréteg-jelnek nevezünk (DLS-double layer sign). A kettősréteg elnevezés itt az egymáshoz viszonylag közel elhelyezkedő RPE-réteget és alatta lévő Bruch-membránt jelenti. A polypoid léziók viszont sub-RPE gyűrűszerű léziókként ábrázolódnak, rendszerint csúcsos, hasadt vagy többszörös PED alatt. FLAG legtöbbször okkult membrán képét mutatja (ritkán, töri át a neovaszkularizáció az RPE-t, akkor ott klasszikus komponens képében jelentkezik), amely rendszerint kevésbé segíti az MNV 1-es típuson belüli PCV altípus meghatározását. A PCV aranystandard diagnosztikus módszere ugyanis az ICGA. A polypoid léziók nodularis hiperfluoreszcenciaként jelennek meg a korai ICGA fázisban (6 percen belül), késői fokozódással (pooling). A BNN detektálása nehezebb, kirajzolásukra a konfokális scanning lézer oftalmoszkóp (cSLO) alapú ICGA a legalkalmasabb, megjelenésük a ICGA korai fázisában várható a polypoid léziók megjelenése előtt. OCTA viszont a BNN ábrázolásában teljesít kimagaslóan, ugyanakkor a polypoid léziók nem mindegyike detektálható jól ezzel a modalitással, mivel rendszerint lassabb bennük az áramlás, mint a készülékek áramlást detektáló alsó határa (6. ábra) (9, 15, 43, 44).


A pachychorioidealis neovasculopathia PCV-hez hasonlóan a pachychorioidealis spektrumbetegségek közé tartozik, ezáltal a lézió alatt itt is megfigyelhetők a tágult pachyerek a Haller-rétegben. A PNV-s betegek rendszerint fiatalabbak a típusos nedves AMD-s betegekhez képest. Prevalenciáját tekintve irodalmi adatok alapján ázsiai populáció esetén 19,5%-26% közötti volt PNV nedves AMD-n belüli előfordulási gyakorisága, míg az irodalomban egyetlen jelenleg fellelhető kaukázusi populáción végzett vizsgálatban ez az arány 20,14% volt (4, 7, 26, 33, 41, 49).
PCV-vel szintén közös vonása, hogy itt is 1-es típusú MNV alakul ki, gyakorlatilag egy polypoid lézió nélküli BNN-ről beszélhetünk. A szemfenéki képen nem specifikus, minimális pigmenteltérések láthatók. OCT-vizsgálattal az 1-es típusú MNV DLS-ként jelenik meg, aktivitására pedig a szintén jól látható subretinalis folyadék (SRF) jelenléte utalhat. FLAG okkult membrán mintázatát mutatja, ICGA rendszerint korai hiperfluoreszcens foltokat és BNN képét mutathatja a tágult chorioideaerek felett, a késő fázisban megjelenő chorioidea hiperpermeabilitással. OCTA a BNN kimutatásában az ICGA-hoz képest szuperior (7. ábra) (29, 36).


Fontos kihangsúlyozni, hogy szemben a többi nedves AMD-ben kialakuló MNV-vel, amelyek kiterjedt druseneket (összefolyó, életlen szélű) és pigmenteltéréseket tartalmaznak, mind PCV mind PNV esetén ezek gyakran hiányoznak, vagy csak olyan kevesebb számú ún. pachydrusen lehet jelen, amelyek élesebb határokkal rendelkeznek irreguláris szélekkel. Ezek mellett ugyanakkor PCV/PNV esetén a kórtörténetben szerepelhet korábbi centrális serosus chorioretinopathia (CSC), valamint a pachychorioidealis kórképekre jellemző egyéb morfológiai eltérések is jelen lehetnek, amelyek fundus autofluoreszcenciával (FAF) még jobban megjeleníthetők (15, 43).
Fentiek után a kaukázusi populációban leggyakrabban előforduló, kb. 50%-os prevalenciával bíró típusos/klasszikus nedves AMD (nAMD) a 2-es típusú MNV-ket, valamint azon 1-es típusú MNV-ket öleli fel, amelyek nem sorolhatók sem PCV-, sem PNV-csoportba (44).
OCT-alapú diagnosztika
Mint láthattuk, a különböző típusú MNV-k differenciálását megkönnyíti a multimodális képalkotás. Bizonyos képalkotó eljárások azonban, mint a FLAG és különösképpen az ICGA, invazív eljárások, mellékhatással járhatnak, időigényesek és nehezebben hozzáférhetők. Éppen ezért értékelődnek fel a non invazív és gyors modalitások, különösképpen az OCT, amely fejlődésének köszönhetően nagy felbontású retina és chorioidea rétegfelvételek létrehozására képes. Mindezek eredőjeként nem meglepő tehát, hogy az utóbbi években kutatócsoportok pusztán OCT-alapú diagnosztikus kritériumokat dolgoztak ki nedves AMD altípusainak differenciálására, amelyek magas szenzitivitással és specificitással rendelkeznek, így megbízhatóan alkalmazhatók a legtöbb esetben. A következőkben ezen OCT kritériumokat mutatjuk be az egyes altípusok diagnosztizálására.
3-as típusú MNV/RAP esetén Kim és munkatársai úttörő vizsgálatot végeztek, amelyben 236 szem elemzése során RAP-léziót PCV-től és típusos nAMD-től 88%-os szenzitivitással és 95%-os specificitással sikerült elkülöníteni ICGA-alapú diagnózissal szemben, amennyiben a következő 5 OCT-kritériumból legalább 3 teljesült:
- subfovealis chorioidealis vastagság <200 µm;
- intraretinalis folyadék (IRF) jelenléte;
- subretinalis folyadék (SRF) hiánya;
- enyhén lejtős domb alakú (a lejtő <45° meredekségű 1:1 pixel méretarányú képen mérve) vagy trapéz alakú PED egyértelmű csúcs nélkül;
- intraretinalis hiperreflektív massza jelenléte (8. ábra) (22).

• subfovealis chorioidealis vastagság <200 µm (sárga csillag),
• intraretinalis folyadék (IRF) jelenléte (fehér nyíl),
• subretinalis folyadék (SRF) hiánya,
• enyhén lejtős domb- vagy trapézalakú pigmentepithel-leválás (PED) egyértelmű csúcs nélkül (fehér csillag),
• intraretinalis hiperreflektív massza jelenléte (sárga nyilak)
PCV esetén több meghatározó vizsgálat is született, amelyeket Permadi és munkatársai 2022-es metaanalízisben elemeztek, és azt találták, hogy pusztán OCT-vel az összevont szenzitivitás elérte a 91%-ot, míg a specificitás a 88%-ot PCV azonosítására. A legrelevánsabb OCT-eltéréseknek PCV esetén a következőket találták:
- hirtelen csúcsosodó PED (legalább egyik oldalán >70°, ismerhetjük még „hüvelykujj alakú” PED-ként is);
- hasadt PED;
- sub-pigmentepithelialis gyűrűszerű elváltozás;
- többszörös PED;
- DLS,
amelyek közül az első 3 a PCV OCT-n látható leggyakoribb, utóbbi kettő pedig kiegészítő jellemzője (9. ábra).

• A kép: hirtelen csúcsosodó PED (fehér nyilak), hasadt PED (sárga nyíl)
• B kép: subpigmentepithelialis gyűrűszerű elváltozás (sárga nyíl)
• C kép: többszörös PED (fehér nyilak), DLS (sárga nyíl), dilatált Haller-réteg-erek (sárga csillagok)
Ezen kívül fontos megemlíteni még az Ázsia-Óceánia Szemészeti Képalkotó Társaság (Asia-Pacific Ocular Imaging Society – APOIS) PCV Munkacsoportjának 2021-ben közölt PCV diagnózisához javasolt nem ICGA-alapú kritériumait. Javaslatuk szerint major és minor kritériumokra bonthatók az eltérések.
Major kritériumok:
- hirtelen csúcsosodó PED;
- sub-pigmentepithelialis gyűrűszerű elváltozás;
- komplex RPE elemelkedés en face OCT-felvételen (ez tulajdonképpen a hiperreflektív BNN által összekapcsolt többszörös PED en face leképezése).
Minor kritériumok:
- DLS;
- komplex vagy multilobularis PED (ez tulajdonképpen a hasadt PED-del azonos);
- vastag chorioidea (subfovealis chorioideavastagság ≥300 µm) vagy dilatált Haller-réteg erek (amelyek a chorioidea szinte teljes egészét elfoglalják a choriokapillárisok elvékonyodását előidézve).
A három major és 1 bármelyik minor kritérium jelenléte esetén vizsgálatuk 78% szenzitivitást és 91% specificitást mutatott PCV helyes diagnosztizálására (5, 8, 37).
A szakirodalomban PNV esetén egyelőre OCT-alapú diagnosztikus kritériumajánlás nem áll rendelkezésre. Ugyanakkor egy a klinikánkon végzett retrospektív vizsgálat során, amelyben 135 nedves AMD-vel újonnan diagnosztizált szem OCT-képeit egymástól függetlenül osztályozta előre megadott OCT-paraméterek alapján két, OCT-vizsgálatban jártas szemész, 85%-os szenzitivitással és 95%-os specificitással sikerült a PNV-esetek elkülönítése. A két OCT vizsgáló eredményei 2 retinaspecialista végső diagnózisával kerültek összevetésre, akik végső diagnózisuk megalkotásához felhasználhatták a betegség kezelése során rendelkezésre álló összes képalkotó modalitást (OCT, OCTA, EDI OCT, FLAG, ICG).
A vizsgálatban használt PNV diagnosztikus OCT-kritériumok a következők voltak:
- DLS;
- SRF jelenléte;
- IRF hiánya;
- vastagodott chorioidea (subfoveális chorioideavastagság ≥300 um) vagy dilatált Haller-réteg erek/pachy vénák (amelyek a chorioidea szinte teljes egészét elfoglalják a choriokapillárisok elvékonyodását előidézve) az MNV alatt.
A PNV diagnózis felállításához minden kritériumnak teljesülni kellett (10. ábra).
• DLS (sárga nyíl), • SRF jelenléte (fehér nyíl),
• IRF hiánya, • vastagabb chorioidea vagy dilatált Haller-réteg- erek (sárga csillagok)
Vizsgálatunk erősíti az OCT szerepét PNV elkülönítésében, ugyanakkor fontosnak tartjuk megjegyezni, hogy az OCT-vizsgálat PNV gyanúja esetén kiegészítendő OCTA-val, az MNV megerősítése, és krónikus CSC-től való elkülönítése miatt.
Megbeszélés
Mint arra a bevezetőben utaltunk, az egyes nedves AMD altípusok és PNV természetes lefolyása, terápiára adott reakciói, valamint funkcionális eredményei eltérőek.
Az 1-es típusú MNV-k akár kezelés nélkül is hosszú hónapokon keresztül stabilak maradhatnak, az esetek 30%-ában akár változatlan látóélességgel (29, 39). Ezzel szemben a 2-es típusú MNV eseteiben a természetes lefolyás súlyos, maradandó látáscsökkenéssel végződhet a subretinalis térben lévő heg következtében. A 3-as típusú MNV, azaz RAP esetén még rosszabb a prognózis, ugyanis 1 éves terápiamentes nyomonkövetés után akár 36%-ban fordulhat elő olyan mértékű látássérülés, amely megfelel a vakság jogi kritériumainak (27, 38, 50). A RAP veszélyességét növeli, hogy az esetek 38%-ában 3 éven belül a másik szem is érintett lesz, míg ez az arány 1-es és 2-es típusú MNV esetén 11%, illetve 6% (3). A PCV esetek egy része kezeletlenül is relatív benignus és nem feltétlenül jár jelentős látásromlással, ugyanakkor az esetek felében kezelés nélkül ismétlődő bevérzéseket láthatunk, amelyek szintén negatívan befolyásolják a kimenetelt (9, 46).
Kezelés esetén sem mindegy melyik altípussal állunk szemben. Legkevesebb injekcióra 2-es típusú MNV esetén van szükség, ugyanakkor a subretinalis fibrosis miatt fontos, hogy ez a jobb prognózis érdekében minél koraibb stádiumban megtörténjen. MNV 1-es típus esetén több injekció szükséges, az SRF jobban tolerálható, valamint a kezelés mellett kialakuló geografikus atrófia is sokkal ritkábban jön létre más típusokkal szemben. A RAP alapvetően jól reagál anti-VEGF-kezelésre, korai stádiuma (I. stádium) kifejezetten kevés injekcióval stabilizálható, a korai stádiumot viszont általában csak a társszemen sikerül elcsípni, a kezelt szem miatti folyamatos monitorizálásnak köszönhetően. Későbbi stádiumokban (II. és III. stádium) viszont az injekciószám növekszik, mivel a rekurrencia aránya is magasabb, mint más MNV esetén. Fontos kiemelni, hogy a geografikus atrófia kialakulásának esélye RAP talaján a legmagasabb, amely akár 77-86%-ot is elérhet több éves kezelés mellett (2, 10, 29, 31, 48). A PCV-esetek jó része jól reagál anti-VEGF-monoterápiára viszonylag nagyobb számú injekcióval. A szemek kb. 10-17%-a, viszont szuboptimális módon reagál, ezért fotodinámiás terápia (PDT), vagy extrafovealis esetekben direkt lézer fotokoagulációs terápia kiegészítés válhat szükségessé (9).
PNV-esetek előnyösebben reagálnak PDT-re, jobb anti-VEGF választ mutatnak, hamarabb kiszáradnak és kevesebb anti-VEGF injekcióra szorulnak, mint a nem-PNV-s szemek. Ennek hátterében szerepet játszhat a VEGF eltérő szerepe is a PNV patomechanizmusában (1, 16, 17, 21, 23 24, 26, 28, 30, 32, 35, 53).
A fentieken túli, másik fontos aspektus az, hogy az egyes nedves AMD altípusok prevalenciája a különböző rasszokban más-más megoszlást mutat. Míg a PCV ázsiaiaknál magas arányú, addig a kaukázusi népcsoportnál a RAP aránya magasabb. PNV esetén még viszonylag kevés adat áll rendelkezésre, de annak aránya irodalmi adatok alapján Európában is elérheti a 20%-ot.
Egy saját, SZTE Szemészeti Klinikán, 135 beteg retrospektív vizsgálata során nyert elemzés alapján a nedves AMD altípusai, beleértve a PNV-t a következő megoszlást mutatták: RAP 23%, PCV 16%, PNV 10%, típusos nAMD 51% (4, 29, 43, 44).
Ezen prevalenciaértékekből és az altípusok eltérő betegséglefolyásából, valamint a terápiára adott eltérő válaszukból is következik, hogy fontos felismernünk a különböző altípusokat.
Egyre több vizsgálat foglalkozik a PNV kérdésével, és a nedves AMD újraklasszifikációjának lehetőségével. Hiszen minden PNV, annak 2015-ös leírása előtt nedves AMD 1-es típusú MNV-ként, akkor még 1-es típusú CNV-ként került diagnosztizálásra az 50 év feletti populációban, maszkolva ezzel a nem pachychorioidealis talajú okkult membránok valódi demográfiai, funkcionális és terápiás eredményeit mind a nagy pivotális nedves AMD-s vizsgálatokban, mind a valóélet-vizsgálatokban (4, 26).
A képet tovább bonyolítja a PCV és PNV kapcsolata, mint pachychorioidealis spektrum betegségek. Ismert ugyanis, hogy PNV hosszú távú fennállása során polypoid léziók jelenhetnek meg és így idővel PCV-be mehet át a betegség. A PCV etiológiáját egyes szerzők így egyenesen két csoportba sorolják, egyrészt előfordulhat PCV pachyerek talaján de novo, vagy PNV-ből átalakulva, másrészt drusen talajú etiológiával is találkozhatunk PCV esetén is, különösen nem ázsiai populációban (11. ábra) (29).

A multimodális képalkotás fejlődésével újabbnál újabb kérdések merülnek fel a diagnosztika terén. Elfogadottá kell tenni a pachychorioidealis szemléletet, ugyanakkor konkrét definíciók és hosszabb távú vizsgálatok szükségesek a pachychorioidealis felfogás tisztázására, a pachychorioidealis betegségek fejlődésének, egymásba való átmenetelének pontosítására, amellyel az osztályba sorolási kritériumok tovább javíthatók. Ehhez a chorioidea még részletesebb képalkotása és elemzése szükséges, további fenotípusok elkülönítése érdekében. Nemzetközi összefogásra van szükség ahhoz, hogy világosan lássuk a rasszok, genetikai és epigenetikai tényezők szerepét ezen kórképek kialakulásában. Nem utolsó sorban pedig chorioidea vezérelt terápiás stratégiák létrehozása is szükséges (9).
Következtetések
Összefoglalva elmondható, hogy a többféle képalkotó eljárás kombinálása segíti a különböző AMD-hez kapcsolódó MNV típusok megkülönböztetését, valamint a PNV felismerését is megkönnyíti. Emellett fontos kiemelni, hogy már önmagában az OCT-alapú biomarkerek is hatékonyan segíthetik a diagnózist, különösen a betegség korai szakaszában. Ezáltal csökkenthető az igény a nehezebben elérhető és invazív képalkotó vizsgálatokra.
Köszönetnyilvánítás
A cikkben megjelenő képek kiválasztásában és szerkesztésében köszönettel tartozunk Héjja Rebeka és Thury Géza doktoroknak.
Nyilatkozat
A szerzők kijelentik, hogy a továbbképző, összefoglaló közleményük megírásával kapcsolatban nem áll fenn velük szemben pénzügyi vagy egyéb lényeges összeütközés, összeférhetetlenségi ok, amely befolyásolhatja a közleményben bemutatott eredményeket, az abból levont következtetéseket vagy azok értelmezését.
Rövidítések:
BNN: branching neovascular network; CNV: chorioidealis neovaszkularizáció; CSC: cenrális serosus chorioretinopathia; DLS: double layer sign; EDI OCT: enhanced depth imaging optikai koherencia tomográfia; FAF: fundus autofluoreszcencia; FLAG: fluoreszcein-angiográfia; ICGA: indocianin zöld angiográfia; IRC: intraretinalis ciszta; IRF: intraretinalis folyadék; MNV: makuláris neovaszkularizáció; nAMD: nedves típusú időskori makuladegeneráció; OCTA: optikai koherencia tomográfia angiográfia; PCV: polypoid chorioidealis vasculopathia; PED: pigmentepithel leválás; PNV: pachychorioidealis neovasculopathia; RAP: retinalis angiomatosus proliferáció; RPE: retinalis pigmentepithelium; SHRM: subretinalis hiperreflektív material; SLO: scanning lézer oftalmoszkóp; SRF: subretinalis folyadék
Irodalom
1. Azuma K, Tan X, Asano S, et al. The association of choroidal structure and its response to anti-VEGF treatment with the short-time outcome in pachychoroid neovasculopathy. PLoS One 2019; 14(2): e0212055. Published 2019 Feb 14.
https://doi.org/10.1371/journal.pone.0212055
2. Baek J, Lee JH, Kim JY, Kim NH, Lee WK. Geographic Atrophy and Activity of Neovascularization in Retinal Angiomatous Proliferation. Invest Ophthalmol Vis Sci 2016; 57(3): 1500–1505.
https://doi.org/10.1167/iovs.15-18837
3. Bochicchio S, Xhepa A, Secondi R, et al. The Incidence of Neovascularization in the Fellow Eye of Patients with Unilateral Choroidal Lesion: A Survival Analysis. Ophthalmol Retina 2019; 3(1): 27–31.
https://doi.org/10.1016/j.oret.2018.08.003
4. Borrelli E, Battista M, Gelormini F, et al. Rate of misdiagnosis and clinical usefulness of the correct diagnosis in exudative neovascular maculopathy secondary to AMD versus pachychoroid disease. Sci Rep 2020; 10(1): 20344. Published 2020 Nov 23.
https://doi.org/10.1038/s41598-020-77566-1
5. Chaikitmongkol V, Khunsongkiet P, Patikulsila D, et al. Color Fundus Photography, Optical Coherence Tomography, and Fluorescein Angiography in Diagnosing Polypoidal Choroidal Vasculopathy. Am J Ophthalmol 2018; 192: 77–83.
https://doi.org/10.1016/j.ajo.2018.05.005
6. Chaikitmongkol V, Sagong M, Lai TYY, et al. Treat-and-Extend Regimens for the Management of Neovascular Age-related Macular Degeneration and Polypoidal Choroidal Vasculopathy: Consensus and Recommendations From the Asia-Pacific Vitreo-retina Society. Asia Pac J Ophthalmol (Phila) 2021; 10(6): 507–518. Published 2021 Nov 24.
https://doi.org/10.1097/APO.0000000000000445
7. Chong Teo KY, Sadda SR, Gemmy Cheung CM, et al. Non-ICGA treatment criteria for Suboptimal Anti-VEGF Response for Polypoidal Choroidal Vasculopathy: APOIS PCV Workgroup Report 2. Ophthalmol Retina 2021; 5(10): 945–953.
https://doi.org/10.1016/j.oret.2021.04.002
8. Cheung CMG, Lai TYY, Teo K, et al. Polypoidal Choroidal Vasculopathy: Consensus Nomenclature and Non-Indocyanine Green Angiograph Diagnostic Criteria from the Asia-Pacific Ocular Imaging Society PCV Workgroup. Ophthalmology 2021; 128(3): 443–452.
https://doi.org/10.1016/j.ophtha.2020.08.006
9. Cheung CMG. Macular neovascularization and polypoidal choroidal vasculopathy: phenotypic variations, pathogenic mechanisms and implications in management. Eye (Lond) 2024; 38(4): 659–667.
https://doi.org/10.1038/s41433-023-02764-w
10. Cho HJ, Yoo SG, Kim HS, et al. Risk factors for geographic atrophy after intravitreal ranibizumab injections for retinal angiomatous proliferation. Am J Ophthalmol 2015; 159(2): 285–92.e1.
https://doi.org/10.1016/j.ajo.2014.10.035
11. Cohen SY, Creuzot-Garcher C, Darmon J, et al. Types of choroidal neovascularisation in newly diagnosed exudative age-related macular degeneration. Br J Ophthalmol 2007; 91(9): 1173–1176.
https://doi.org/ 10.1136/bjo.2007.115501
12. Dansingani KK, Balaratnasingam C, Klufas MA, Sarraf D, Freund KB. Optical Coherence Tomography Angiography of Shallow Irregular Pigment Epithelial Detachments In Pachychoroid Spectrum Disease. Am J Ophthalmol 2015; 160(6): 1243–1254.e2.
https://doi.org/10.1016/j.ajo.2015.08.028
13. Demirel S, Yanık Ö, Nalcı H, Batıoğlu F, Özmert E. The use of optical coherence tomography angiography in pachychoroid spectrum diseases: a concurrent comparison with dye angiography. Graefes Arch Clin Exp Ophthalmol 2017; 255(12): 2317–2324.
https://doi.org/10.1007/s00417-017-3793-8
14. Gass JD. Pathogenesis of disciform detachment of the neuroepithelium. Am J Ophthalmol 1967; 63(3): 1–139.
15. Gergely R, Ecsedy M, Kovács I, Papp A, Resch M, Récsán Z, Szabó A, Nagy ZZ. Pachychorioidealis kórképek [Pachychoroid diseases]. Orv Hetil 2021 May 16; 162(20): 770–781. Hungarian
16. Hata M, Yamashiro K, Ooto S, et al. Intraocular Vascular Endothelial Growth Factor Levels in Pachychoroid Neovasculopathy and Neovascular Age-Related Macular Degeneration. Invest Ophthalmol Vis Sci 2017; 58(1): 292–298.
https://doi.org/10.1167/iovs.16-20967
17. Hikichi T, Kubo N, Yamauchi M. One-year comparison of anti-vascular endothelial growth factor and half-dose photodynamic therapies for pachychoroid neovasculopathy. Eye (Lond) 2021; 35(12): 3367–3375.
https://doi.org/10.1038/s41433-021-01418-z
18. Huang D, Swanson EA, Lin CP, et al. Optical coherence tomography. Science 1991; 254(5035): 1178–1181.
https://doi.org/10.1126/science.1957169
19. Inoue M, Balaratnasingam C, Freund KB. Optical coherence tomography angiography of polypoidal choroidal vasculopathy and polypoidal choroidal neovascularization. Retina 2015; 35(11): 2265–2274.
https://doi.org/10.1097/IAE.0000000000000777
20. Izquierdo-Serra J, Martin-Pinardel R, Moll-Udina A, et al. Macular Neovascularization Type Influence on Anti-VEGF Intravitreal Therapy Outcomes in Age-Related Macular Degeneration. Ophthalmol Retina 2024; 8(4): 350–359.
https://doi.org/10.1016/j.oret.2023.10.022
21. Karasu B, Celebi ARC. An efficacy comparison of combination of different anti-vascular endothelial growth factors and photodynamic therapy in patients with pachychoroid neovasculopathy. Int Ophthalmol 2021; 41(6): 1989–2000.
https://doi.org/10.1007/s10792-021-01754-9
22. Kim JH, Chang YS, Kim JW, Lee TG, Kim HS. Diagnosis of type 3 neovascularization based on optical coherence tomography images. Retina 2016; 36(8): 1506–1515.
https://doi.org/10.1097/IAE.0000000000000932
23. Kinoshita T, Mori J, Hatanaka A, Shimizu M, Imaizumi H. Visual Outcome and Treatment Frequency of Anti-VEGF Therapy Using the Treat-and-Extend and Treatment Cessation Regimen for Exudative Age-Related Macular Degeneration and Pachychoroid Neovasculopathy. Clin Ophthalmol 2021; 15: 4405–4418. Published 2021 Nov 9.
https://doi.org/10.2147/OPTH.S334641
24. Kitajima Y, Maruyama-Inoue M, Ito A, et al. One-year outcome of combination therapy with intravitreal anti-vascular endothelial growth factor and photodynamic therapy in patients with pachychoroid neovasculopathy. Graefes Arch Clin Exp Ophthalmol 2020; 258(6): 1279–1285.
https://doi.org/10.1007/s00417-020-04661-4
25. Klein R, Peto T, Bird A, Vannewkirk MR. The epidemiology of age-related macular degeneration. Am J Ophthalmol 2004; 137(3): 486–495.
https://doi.org/10.1016/j.ajo.2003.11.069
26. Kuranami A, Maruko R, Maruko I, Hasegawa T, Iida T. Pachychoroid neovasculopathy has clinical properties that differ from conventional neovascular age-related macular dege- neration. Sci Rep 2023; 13(1): 7379. Published 2023 May 6.
https://doi.org/10.1038/s41598-023-33936-z
27. Laser photocoagulation of subfoveal neovascular lesions in age-related macular degeneration. Results of a randomized clinical trial. Macular Photocoagulation Study Group. Arch Ophthalmol 1991; 109(9): 1220–1231.
https://doi.org/10.1001/archopht.1991.01080090044025
28. Lee JH, Lee WK. One-year results of adjunctive photodynamic therapy for type 1 neovascularization associated with thickened choroid. Retina 2016; 36(5): 889–895.
https://doi.org/10.1097/IAE.0000000000000809
29. Mathis T, Holz FG, Sivaprasad S, et al. Characterisation of macular neovascularisation subtypes in age-related macular degeneration to optimise treatment outcomes. Eye (Lond) 2023; 37(9): 1758–1765.
https://doi.org/10.1038/s41433-022-02231-y
30. Matsumoto H, Hiroe T, Morimoto M, Mimura K, Ito A, Akiyama H. Efficacy of treat-and-extend regimen with aflibercept for pachychoroid neovasculopathy and Type 1 neovascular age-related macular degeneration. Jpn J Ophthalmol 2018; 62(2): 144–150.
https://doi.org/10.1007/s10384-018-0562-0
31. McBain VA, Kumari R, Townend J, Lois N. Geographic atrophy in retinal angiomatous proliferation. Retina 2011; 31(6): 1043–1052.
https://doi.org/10.1097/IAE.0b013e3181fe54c7
32. Miki A, Kusuhara S, Otsuji T, et al. Photodynamic therapy combined with anti-vascular endothelial growth factor therapy for pachychoroid neovasculopathy. PLoS One 2021; 16(3): e0248760. Published 2021 Mar 23.
https://doi.org/10.1371/journal.pone.0248760
33. Miyake M, Ooto S, Yamashiro K, et al. Pachychoroid neovasculopathy and age-related macular degeneration. Sci Rep 2015; 5: 16204. Published 2015 Nov 6.
https://doi.org/10.1038/srep16204
34. Nakashizuka H, Mitsumata M, Okisaka S, et al. Clinicopathologic findings in polypoidal choroidal vasculopathy. Invest Ophthalmol Vis Sci 2008; 49(11): 4729–4737.
https://doi.org/10.1167/iovs.08-2134
35. Padrón-Pérez N, Arias L, Rubio M, et al. Changes in Choroidal Thickness After Intravitreal Injection of Anti-Vascular Endothelial Growth Factor in Pachychoroid Neovasculopathy. Invest Ophthalmol Vis Sci 2018; 59(2): 1119–1124.
https://doi.org/10.1167/iovs.17-22144
36. Pang CE, Freund KB. Pachychoroid neovasculopathy. Retina 2015; 35(1): 1–9.
https://doi.org/10.1097/IAE.0000000000000331
37. Permadi AC, Djatikusumo A, Adriono GA. Optical coherence tomography in diagnosing polypoidal choroidal vasculopathy. Looking into the future: a systematic review and meta-analysis. Int J Retina Vitreous 2022; 8(1): 14. Published 2022 Feb 28.
https://doi.org/10.1186/s40942-022-00365-5
38. Photodynamic therapy of subfoveal choroidal neovascularization in age-related macular degeneration with verteporfin: one-year results of 2 randomized clinical trials--TAP report. Treatment of age-related macular degeneration with photodynamic therapy (TAP) Study Group [published correction appears in Arch Ophthalmol 2000 Apr; 118(4): 488]. Arch Ophthalmol 1999; 117(10): 1329–1345.
39. Polito A, Isola M, Lanzetta P, Gregori D, Bandello F. The natural history of occult choroidal neovascularisation associated with age-related macular degeneration. A systematic review. Ann Acad Med Singap 2006; 35(3): 145–150.
40. Qiang W, Wei R, Chen Y, Chen D. Clinical Pathological Features and Current Animal Models of Type 3 Macular Neovascularization. Front Neurosci. 2021; 15: 734860. Published 2021 Aug 26.
https://doi.org/10.3389/fnins.2021.734860
41. Sartini F, Figus M, Casini G, Nardi M, Posarelli C. Pachychoroid neovasculopathy: a type-1 choroidal neovascularization belonging to the pachychoroid spectrum-pathogenesis, imaging and available treatment options. Int Ophthalmol 2020; 40(12): 3577–3589.
https://doi.org/10.1007/s10792-020-01522-1
42. Schmidt-Erfurth U, Waldstein SM. A paradigm shift in imaging biomarkers in neovascular age-related macular degeneration. Prog Retin Eye Res 2016; 50: 1–24.
https://doi.org/10.1016/j.preteyeres.2015.07.007
43. Sheth JU, Stewart MW, Narayanan R, et al. Macular neovascularization. Surv Ophthalmol Published online August 31, 2024.
https://doi.org/10.1016/j.survophthal.2024.08.003
44. Spaide RF, Jaffe GJ, Sarraf D, et al. Consensus Nomenclature for Reporting Neovascular Age-Related Macular Degeneration Data: Consensus on Neovascular Age-Related Macular Degeneration Nomenclature Study Group [published correction appears in Ophthalmology. 2020 Oct; 127(10): 1434–1435.
https://doi.org/10.1016/j.ophtha.2020.07.019.] . Ophthalmology 2020; 127(5): 616–636.
https://doi.org/10.1016/j.ophtha.2019.11.004
45. Tsai ASH, Cheung N, Gan ATL, et al. Retinal angiomatous proliferation. Surv Ophthalmol 2017; 62(4): 462–492.
https://doi.org/10.1016/j.survophthal.2017.01.008
46. Uyama M, Wada M, Nagai Y, et al. Polypoidal choroidal vasculopathy: natural history. Am J Ophthalmol 2002; 133(5): 639–648.
https://doi.org/10.1016/s0002-9394(02)01404-6
47. Wang M, Zhou Y, Gao SS, et al. Evaluating Polypoidal Choroidal Vasculopathy With Optical Coherence Tomography Angiography. Invest Ophthalmol Vis Sci 2016; 57(9): OCT526–OCT532.
https://doi.org/10.1167/iovs.15-18955
48. Xu L, Mrejen S, Jung JJ, et al. Geographic atrophy in patients receiving anti-vascular endothelial growth factor for neovascular age-related macular degeneration. Retina 2015; 35(2): 176–186.
https://doi.org/10.1097/IAE.0000000000000374
49. Yanagi Y. Pachychoroid disease: a new perspective on exudative maculopathy. Jpn J Ophthalmol 2020; 64(4): 323–337.
https://doi.org/10.1007/s10384-020-00740-5
50. Yannuzzi LA, Freund KB, Takahashi BS. Review of retinal angiomatous proliferation or type 3 neovascularization. Retina 2008; 28(3): 375–384.
https://doi.org/10.1097/IAE.0b013e3181619c55
51. Yannuzzi LA, Negrão S, Iida T, et al. Retinal angiomatous proliferation in age-related macular degeneration. Retina 2001; 21(5): 416–434.
https://doi.org/10.1097/00006982-200110000-00003
52. Yannuzzi LA, Sorenson J, Spaide RF, Lipson B. Idiopathic polypoidal choroidal vasculopathy (IPCV). Retina 1990; 10(1): 1–8.
53. Yoon J, Yoon W, Na SK, et al. Long-term outcome of intravitreal anti-vascular endothelial growth factor treatment for pachychoroid neovasculopathy [published correction appears in Sci Rep 2021 Sep 14; 11(1): 18647.
https://doi.org/10.1038/s41598-021-98358-1.] . Sci Rep. 2021; 11(1): 12052. Published 2021 Jun 8.
https://doi.org/10.1038/s41598-021-91589-2